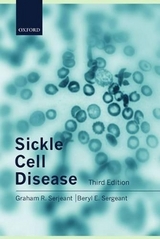
Sickle Cell Disease - Serjeant, Graham R.; Serjeant, Beryl E.

Sickle Cell Disease
Oxford University Press (Verlag)
978-0-19-262232-7 (ISBN)
- Titel erscheint in neuer Auflage
- Artikel merken
Sickle cell disease was one of the first diseases to be explained at the molecular level. Nevertheless, in the years since the first edition of this book was published, further advances have been made. Much has been learnt about the causes of variability in the natural history of the disease and of the reasons why there are such marked variations in the patterns of morbidity and mortality. The role and importance of genetic modifiers such as alpha thalassaemia and persisting high levels of fetal haemoglobin, and of the beta globin haplotype, have been recognized and explored. Studies of the disease which compare geographically separated populations have contributed to understanding this variability. These findings have led to more rigorous thinking about the nature of the disease and a clearer appreciation of how to manage it.
Basic concepts; distribution of sickle cell disease; nomenclature and genetics of sickle cell disease; diagnosis of sickle cell disease; pathophysiology of sickle cell disease; historical concepts; the bone marrow; the blood; the liver; the spleen; the immune system; the gut; cardiovascular system; pulmonary system; leg ulceration; bone and joint lesions; the painful crisis; renal manifestations; priapism; the nervous system; the eyes; physical and sexual development; pregnancy and contraception; endocrine system, metabolism and nutrition; homozygous sickle cell disease; sickle cell - haemoglobin C disease; sickle cell - beta thalassaemia type III; other forms of sickle cell disease; sickle cell - hereditary persistence of fetal haemoglobin; the sickle cell trait; general supportive measures; transfusion; attempts to inhibit sickling; surgery and anaesthesia; screening and sickle cell clinics; age and patterns of clinical involvement; causes of death; natural history.
| Erscheint lt. Verlag | 17.9.1992 |
|---|---|
| Zusatzinfo | frontispiece, numerous halftones, line drawings, tables, bibliography |
| Verlagsort | Oxford |
| Sprache | englisch |
| Maße | 160 x 230 mm |
| Gewicht | 1160 g |
| Themenwelt | Medizinische Fachgebiete ► Innere Medizin ► Hämatologie |
| Studium ► 2. Studienabschnitt (Klinik) ► Humangenetik | |
| ISBN-10 | 0-19-262232-3 / 0192622323 |
| ISBN-13 | 978-0-19-262232-7 / 9780192622327 |
| Zustand | Neuware |
| Informationen gemäß Produktsicherheitsverordnung (GPSR) | |
| Haben Sie eine Frage zum Produkt? |
aus dem Bereich